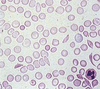

Local IM Exam review Flashcards
1
Q

A
-Pneumonia
2
Q

A
-Pleural effusion
3
Q

A
-pneumothorax
4
Q

A
-Pulmonary edema
5
Q

A
-Congestive heart failure
6
Q

A
-cardiomegaly
7
Q

A
-interstitial lung disease
8
Q

A
-lung tumor
9
Q

A
- atelectasis
- lung collapse
- appearse more dense on CXR
10
Q

A
- Iron deficiency anemia
- microcytosis
- the size of the RBC is = to the nucleus of a lymphocyte
11
Q

A
-macrocytic anemia
12
Q
A
-sickle cell anemia
13
Q

A
- Thalassemia
- microcytosis plus target cells
14
Q

A
- TTP
- schistocytosis
15
Q

A
-sphereocytosis
16
Q

A
-Malaria
17
Q

A
- Mono
- atypical lymphocytes
18
Q

A
- plasma cell dyscrasia
- multiple myeloma
19
Q

A
- rouleax
- multiple myelomma
20
Q

A
- Auer rod
- AML
21
Q

A
- CLL
- smudge cell
22
Q

A
-Harry cell leukemia
23
Q

A
- gram stain
- strep pneumoniae
- gram positive dipplococci
24
Q

A
- H. influenzae
- gram negative coccibacillus
25
Q

A
- Staph species
- gram positive cocci in clusters
26
Q

A
- klebsiella pneumoniae
- gram negative rods
27
Q
Acid fast stain
A
-M. tuberculosis
28
Q

A
- gram negative rods in the urine
- E.coli, proteus, etc.
29
Q

A
- A = hyaline cast
- B = erythrocyte cast
- C = Leukocyte cast
- D = granular cast
30
Q

A
Urinalysis crystals:
- A = calcium oxalate –> seen with ethylene glycol poisoning
- B = uric acid
- C = triple phosphate –> alkaline urine, proteus UTI
- D = cystine
31
Q
Urinalysis

A
- epithelial cells (arrows)
- leukocytes
32
Q

A
Gonococci
33
Q

A
Candida
34
Q

A
-trichomonas
35
Q

A
- bacterial vaginosis
- clue cells
36
Q

A
- herpes
- use tzanck stain to detect the multinucleated giant cells
37
Q

A
- syphilis
- treponema pallidum
- spirochete is seen under Darkfeild
38
Q

A
- Chancroid
- caused by haemophilus ducreyi
39
Q

A
- chlamydia trachomatis
- obligate intracellular organism
40
Q

A
-scabies
41
Q

A
- lice
- able to see with naked eye!
42
Q
A